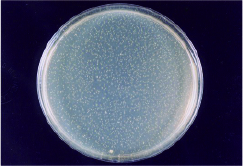

詳細

シユッとスプレーするだけで、植物より抽出された消臭成分がイヤな臭いをすばやく消し去るとともに、臭いのもととなる微生物を抑制します。浮遊するカビの胞子を吸い込むと肺炎になりますので、室内や車室内の噴霧をお勧めします。MRSAやSARS対策としても有効です。病原菌、ウイルス対策として噴霧することをお勧めします。 ペットの臭いや感染症対策としてもお勧めできます。幼児にも安心のスプレーです。
除菌
消臭
抗菌
防菌
特徴
カビに対して効果抜群
医療現場から生まれた画期的抗菌消臭剤
ノンアルコール無香料
重症急性呼吸器症候群(SARS)対策
用途
手指、マスク、靴、衣服、介護用品、玩具、キッチン用品、室内家具、トイレ、ペット用品、生ゴミ臭、床面、壁面等の除菌・消臭
製品情報
品名:銀イオン抗菌消臭液
内容量:300ml
成分:精製水・植物抽出液・銀
液性:弱酸性
食品添加物由来
詰替え用


医療現場から生まれた画期的抗菌消臭剤

MRSA 保存24時間後 検体噴霧あり
MRSA 保存24時間後 検体噴霧なし
MRSAに対する銀イオンの効果
抗菌力試験
試験菌 | 測定 | 検体噴霧 | プラスチックシャーレ 一枚あたりの生菌数 |
MRSA | 保存前 | なし | 1.2×105 |
室温20分保存後 | あり なし |
<10 1.3×105 |
|
室温24時間保存後 | あり なし |
<10 7.0×105 |

MRSA 保存20分後 検体噴霧あり

MRSA 保存20分後 検体噴霧なし

MRSA 保存24時間後 検体噴霧あり

MRSA 保存24時間後 検体噴霧なし
(財)日本食品分析センター
AG21スペシャル&Ag moist 消臭試験
硫化水素 | メチルメルカプタン | アンモニア | ニコチン | トリメチルアミン | n−酪酸 | ||
AG21スペシャル &Ag moist |
残存臭気濃度(ppm) 消臭率(%) |
0.4 86.7 |
0.5 86.8 |
225 98.6 |
3.3 79.4 |
0.2 99.7 |
4.2 99.1 |
他社代表品 (化学系) |
残存臭気濃度(ppm) 消臭率(%) |
1.1 69.3 |
1.6 57.9 |
1.250 92.0 |
8.5 46.9 |
0.2 99.7 |
3.4 99.2 |
他社代表品 (植物系) |
残存臭気濃度(ppm) 消臭率(%) |
3.1 0.0 |
2.5 31.6 |
2.100 86.7 |
21.0 0.0 |
0.2 99.7 |
1.0 99.2 |
ブランク | 濃度(ppm) | 3.0 | 3.8 | 15.600 | 16.0 | 350 | 450 |
大阪市立環境科学研究所
銀イオンの除菌抗菌消臭液はSARS対策で話題になりました!!
2004年 中国のSARS対策(国家プロジェクト)において、世界中から選出された薬剤があつめられて、それぞれ30種類に 及ぶ検査が行われた結果、無害で高い効力と持続力を有する銀イオン水溶液(環境サイエンス製造)がAランク中に選ばれました。
☆Aランク5社(アメリカ:3社、ドイツ:1社、日本:1社)の 薬剤中、無害の薬剤は環境サイエンス(株)の製品だけでした。
環境サイエンス(株)製造「銀イオン水溶液」の実績 重症急性呼吸器症候群(SARS)対策として 大手旅行会社に採用されました。 愛知万博のスウェットタオルディスペンサーの 除菌液として、採用されました。 ※現在、警視庁に納入されています。(納入品名:Agモイスト)